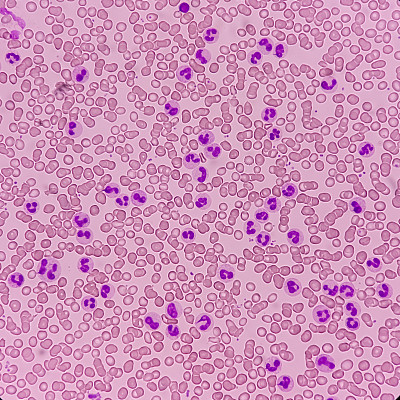

血液学

请先登录后再下载
58明星,血液学,血液样本,装管,艾滋病病毒,生物化学,实验室设备,医学样本,微生物学,化学,科学实验,实验室,药水瓶,医学研究,医学检测,病毒,化学制品,血液,科学,癌症,生物学,生物科技,结论,研究,身体状况,白血病,药,分析,医院,健康保健,设备用品,身体检查,生病,医疗用品,液体,红色,表格,文档,无人,水平画幅,科技,关爱,摄影,图像,4K分辨率